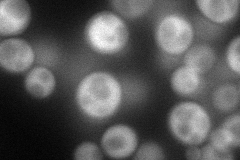
YER139C

View description
CTD phosphatase; dephosphorylates S5-P in the C-terminal domain of Rpo21p; has a cysteine-rich motif required for function and conserved in eukaryotes; shuttles between the nucleus and cytoplasm
Localization:
Intensity:
Fold change:
Significance:
-
C’ GFP library in SD

below threshold16.05 -
N' NOP1pr-GFP in SD
cytosol86.109 -
N' TEF2pr-mCherry in SD

cytosol118.7 -
N' NATIVEpr-GFP in SD

missing0 -
N' TEF2pr-VC and Cyto-VN in SD

#N/A0 -
C’ GFP library in SD+DTT

cytosol17.261.07No -
C’ GFP library in SD+H2O2

cytosol14.980.93No -
C’ GFP library in Starvation Media

cytosol17.231.07No -
C’ GFP library on the background of Pup2-DaMP

below threshold -
C’ GFP library on the background of CCT mutant

below threshold16.07091.00067No
